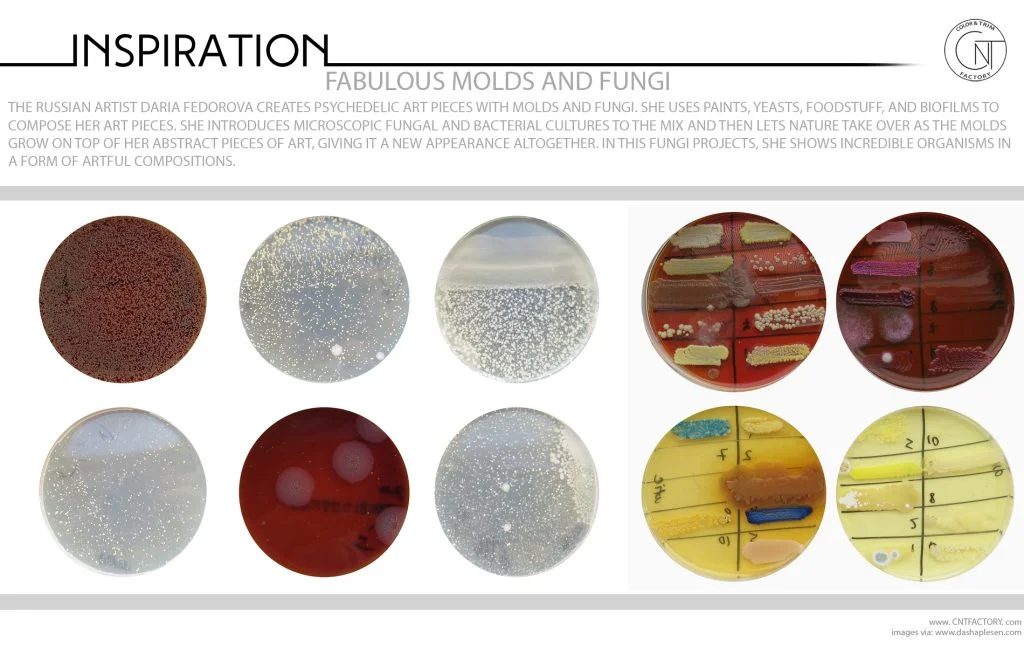
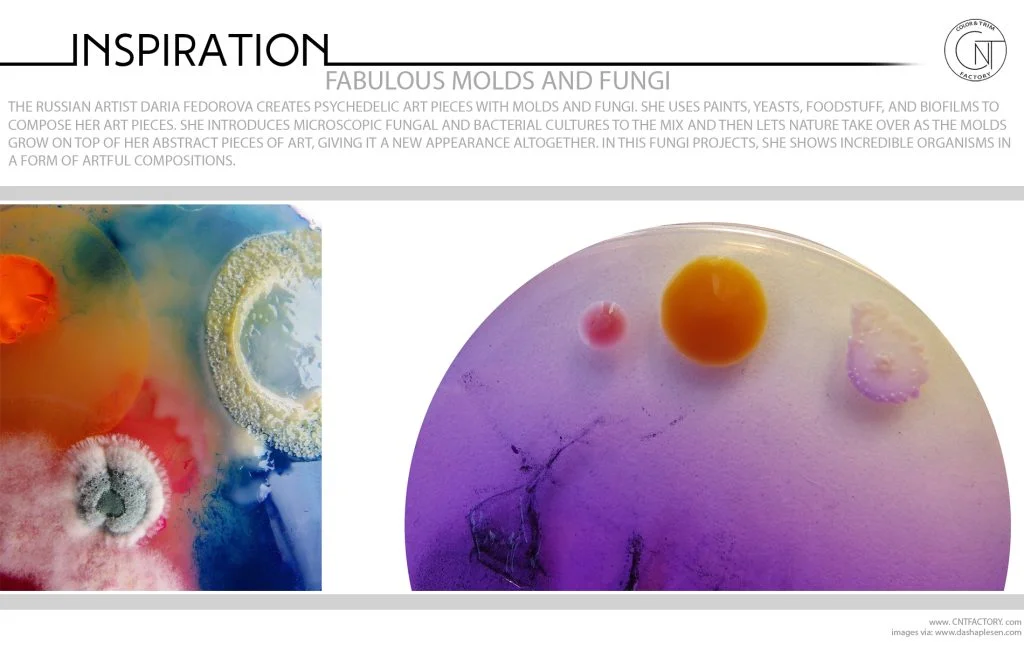
Fabulous Molds And Fungi
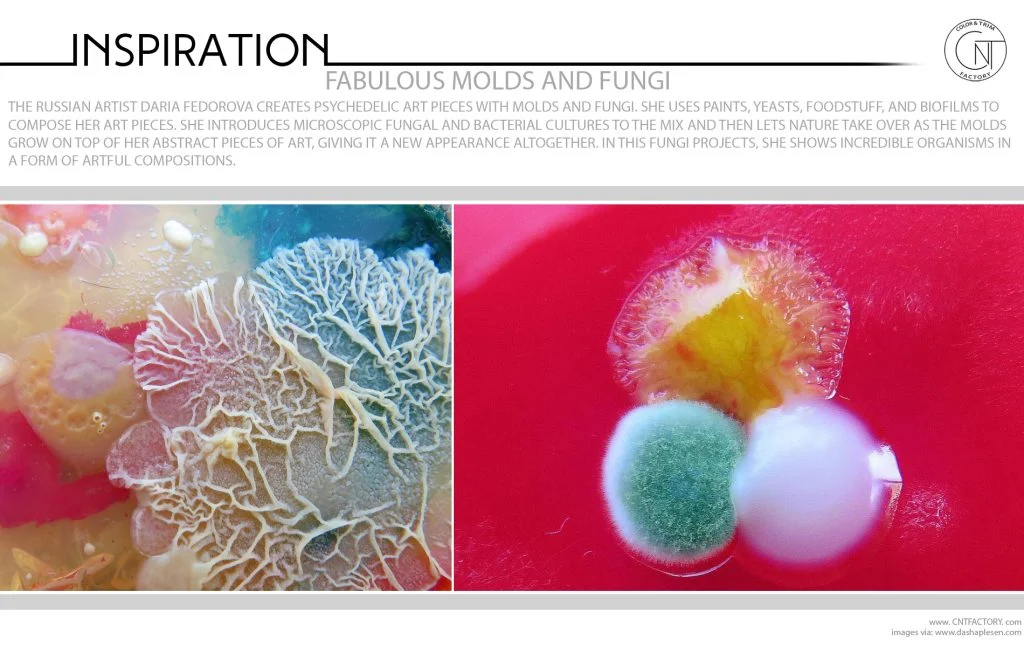
Fabulous Molds And Fungi
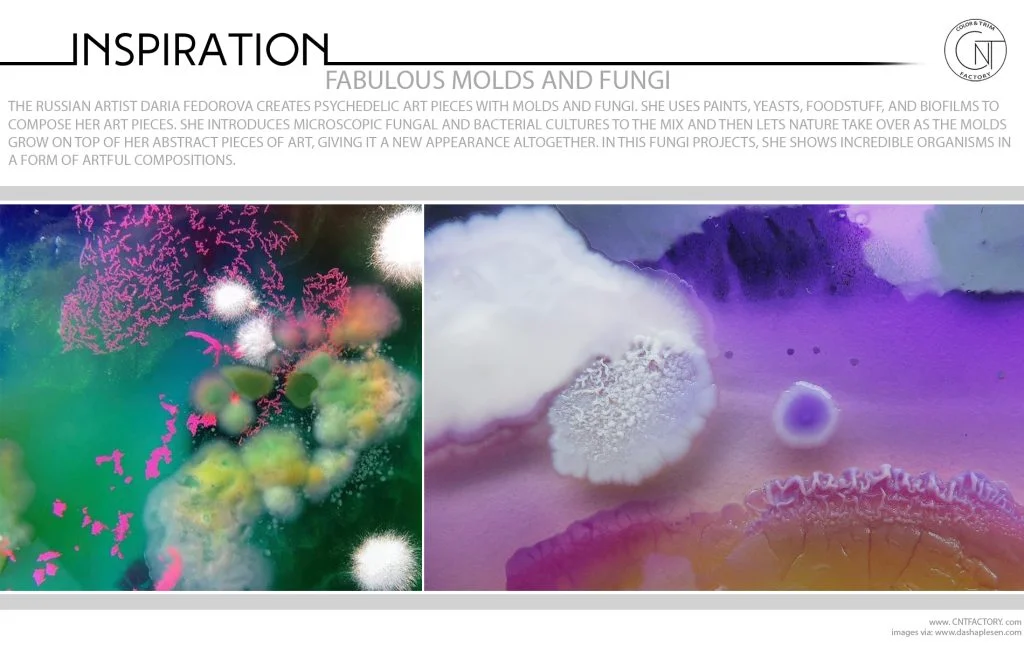
Fabulous Molds And Fungi
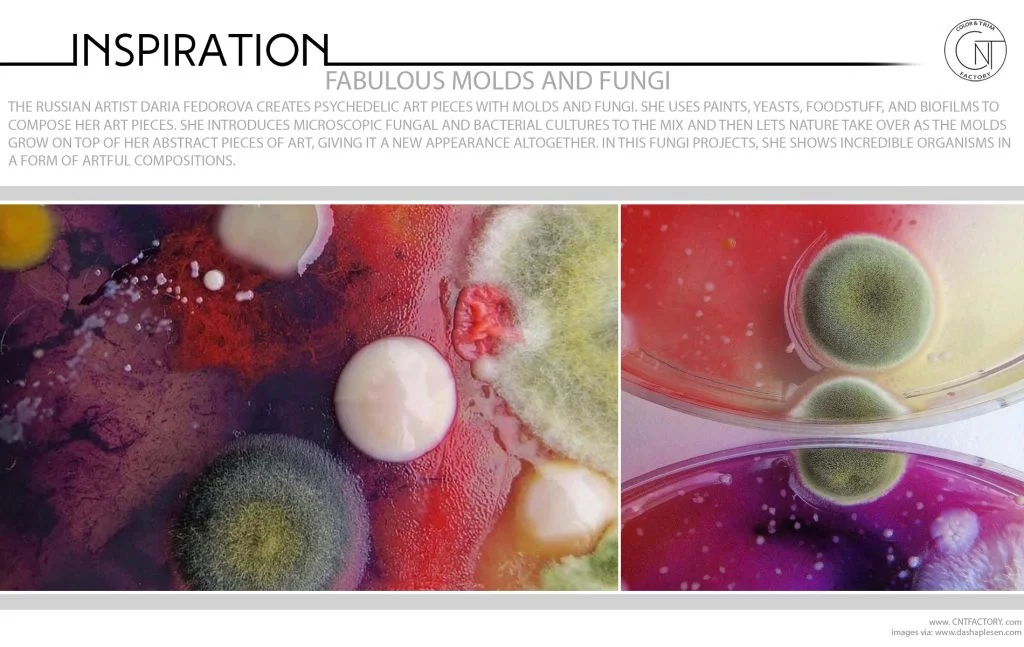
Fabulous Molds And Fungi
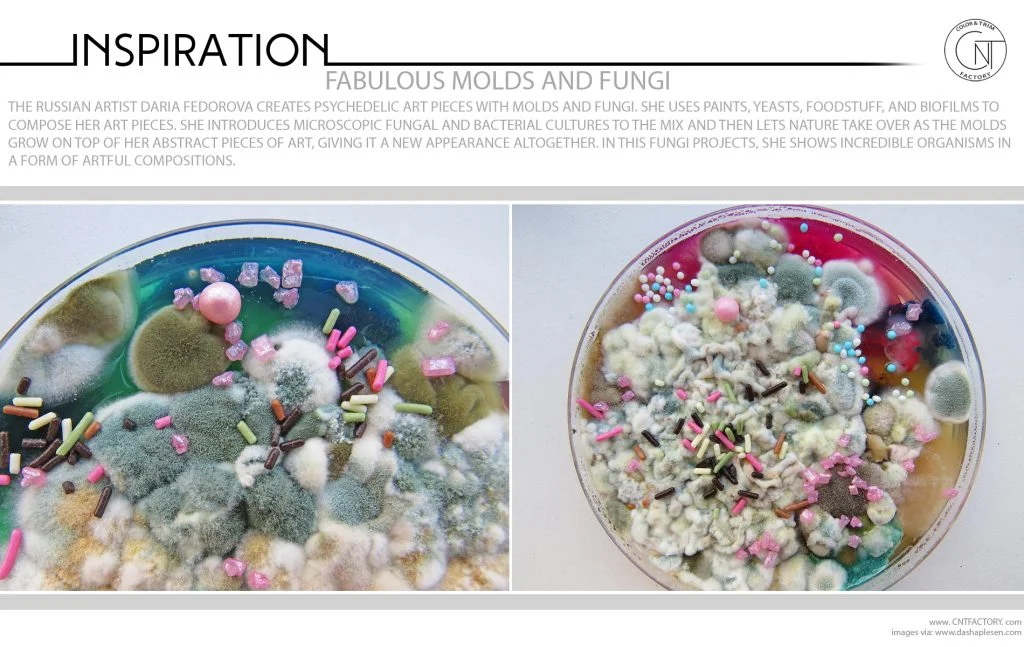
Fabulous Molds And Fungi

Related Post: Tactile Volcanic Rock / Maison & Objet / Concrete
The Russian artist Daria Fedorova creates psychedelic art pieces with molds and fungi. She uses paints, yeasts, foodstuff, and biofilms to compose her art pieces. She introduces microscopic fungal and bacterial cultures to the mix and then lets nature take over as the molds grow on top of her abstract pieces of art, giving it a new appearance altogether. In this Fungi projects, she shows incredible organisms in a form of artful compositions.